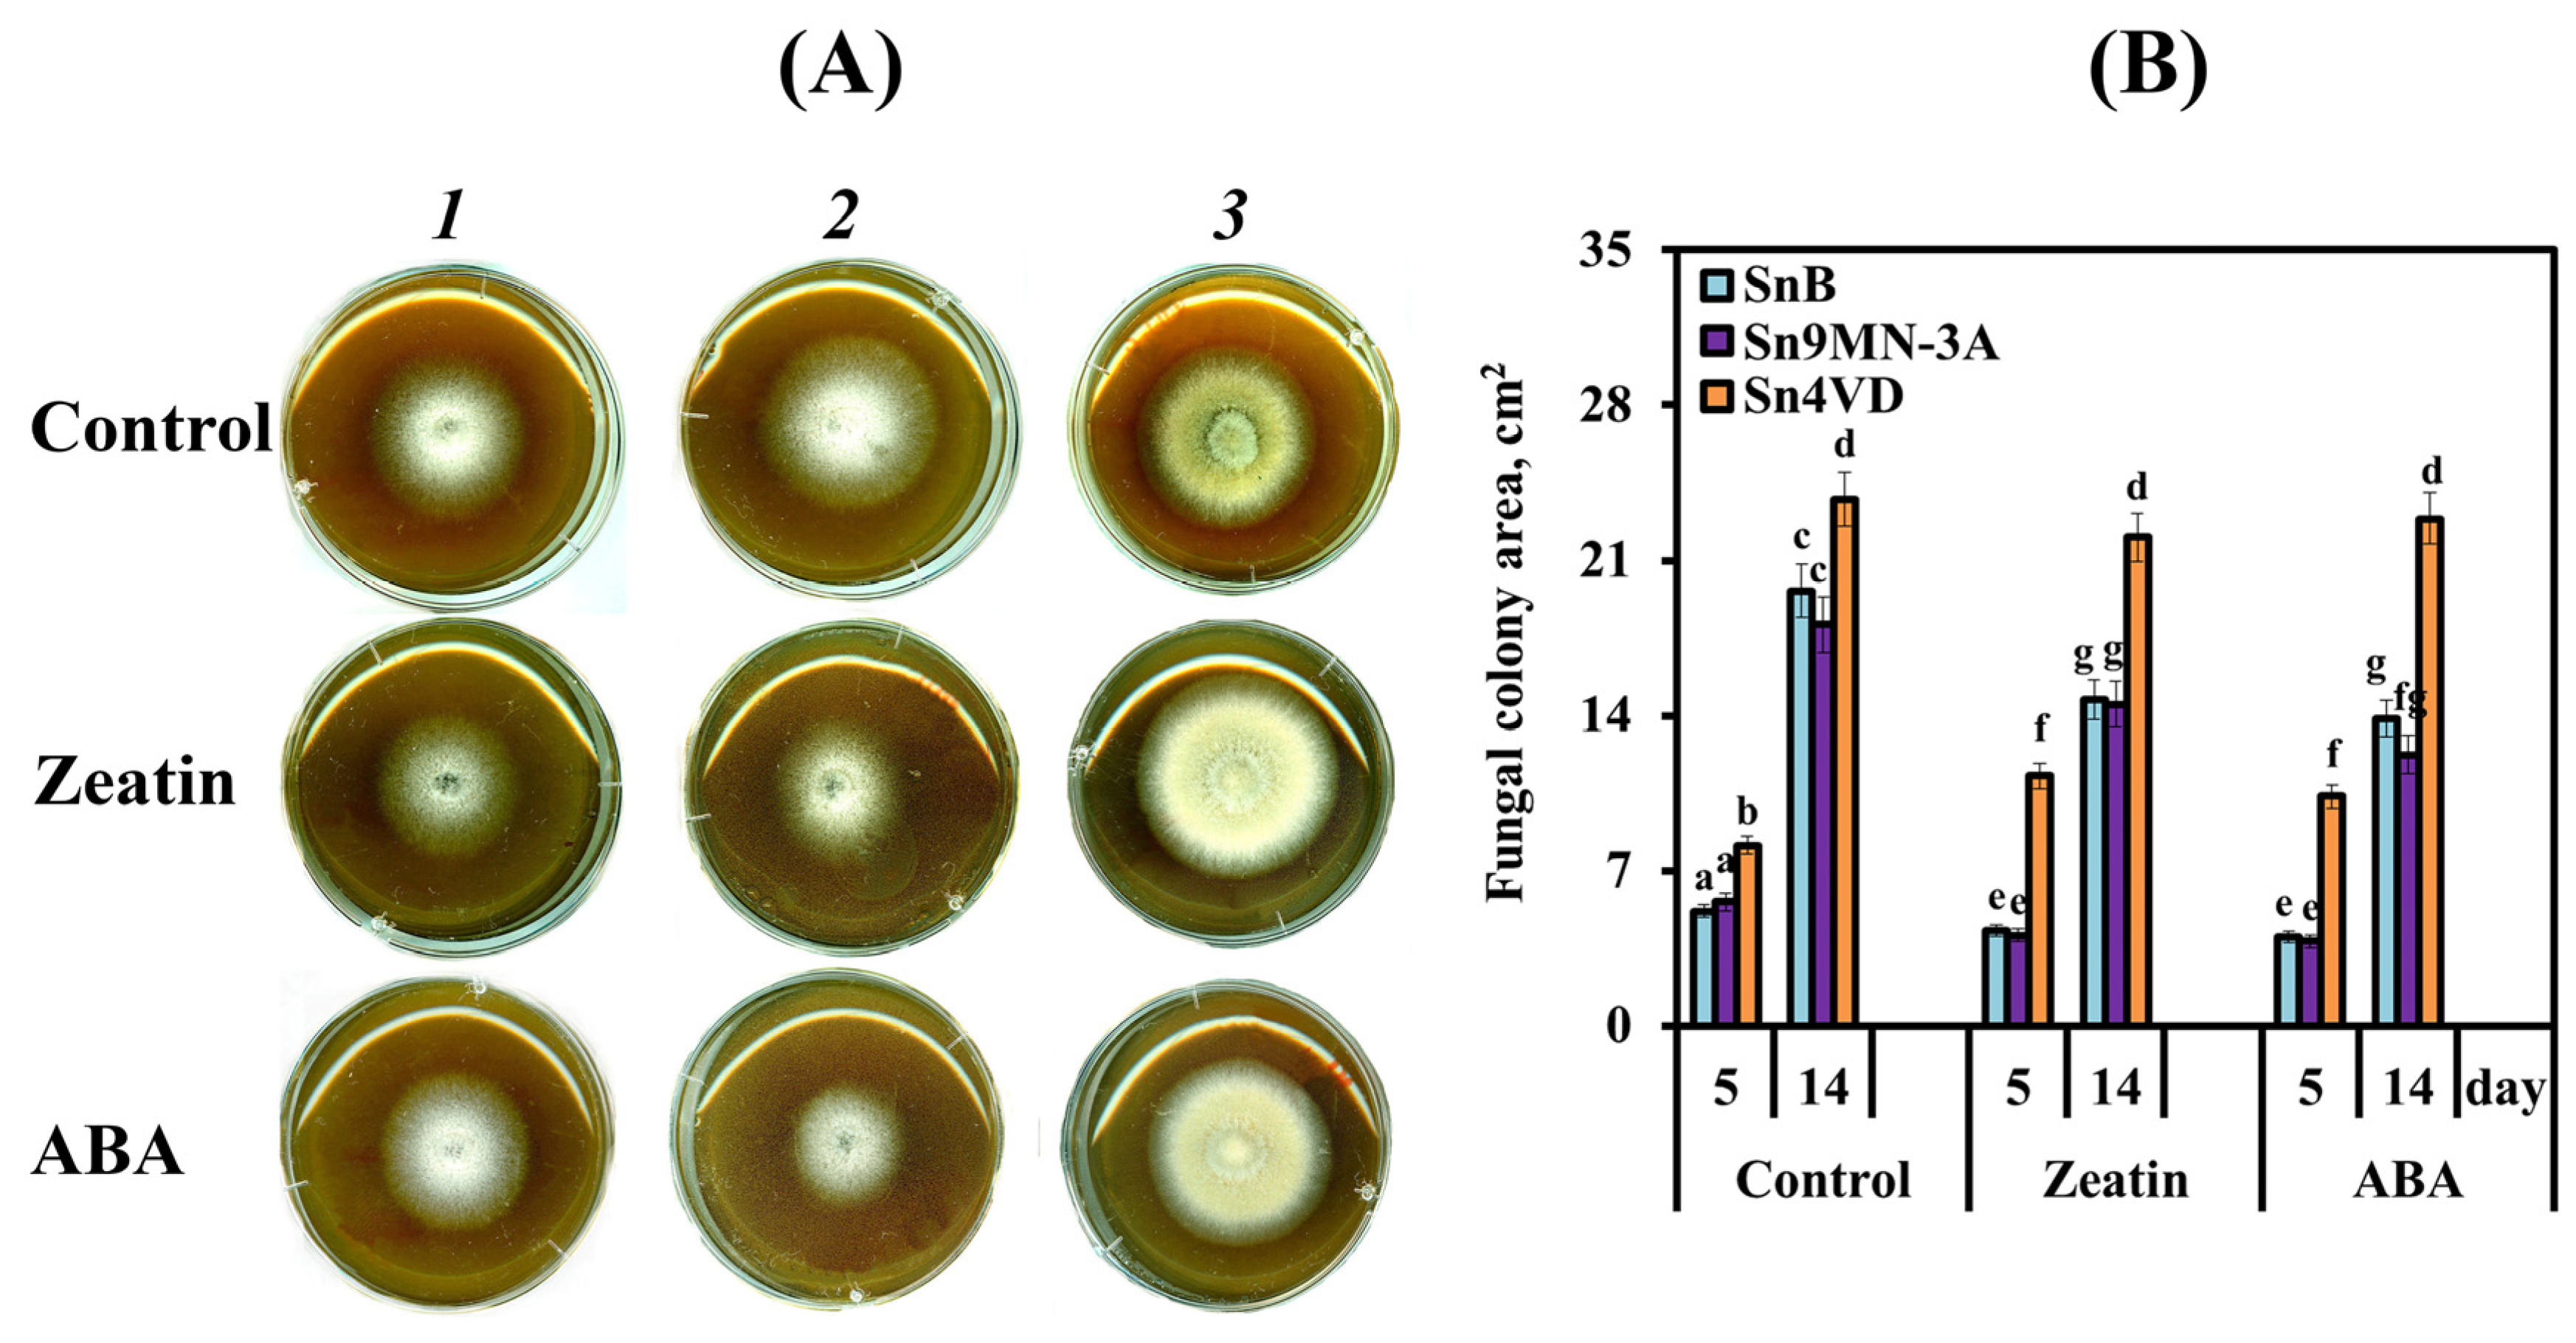

The Role of Cytokinins and Abscisic Acid in the Growth, Development and Virulence of the Pathogenic Fungus Stagonospora nodorum (Berk.)
Abstract
1. Introduction
2. Materials and Methods
2.1. Fungi Material and Growth Conditions
2.2. Assay of the Fungal-Derived Hormone Content in the Mycelium and Liquid Culture Medium of S. nodorum
2.3. Assay of Growth Characteristics and Sporulation in S. nodorum Isolates
2.4. Assay of Gene Expression
2.5. Statistical Analysis
3. Results
3.1. Ability of Different Isolates of S. nodorum to Produce Hormones
3.2. The Influence of Zeatin and ABA on the Growth and Sporulation of the Pathogen S. nodorum
3.2.1. Selection of Concentrations of Zeatin and ABA Affecting the Growth and Sporulation of the Pathogen
3.2.2. Effect of Zeatin and ABA on Mycelial Growth and Sporulation of S. nodorum Isolates
3.2.3. The Role of Carbohydrate Metabolism Enzymes in Sporulation of S. nodorum SnB
3.2.4. The Influence of Zeatin and ABA on the Expression of Genes Encoding Enzymes of Carbohydrate Metabolism
3.3. The Influence of Zeatin and ABA on the Expression of Genes Encoding NEs and TFs of S. nodorum Isolates
4. Discussion
4.1. Why Do Fungi Need Hormones?
4.2. The Influence of CKs and ABA on the Growth and Sporulation of S. nodorum
4.3. The Influence of CKs and ABA on the Virulence Factors of the Fungus S. nodorum
5. Conclusions
Supplementary Materials
Author Contributions
Funding
Institutional Review Board Statement
Informed Consent Statement
Data Availability Statement
Acknowledgments
Conflicts of Interest
References
- Robert-Seilaniantz, A.; Grant, M.; Jones, J.D.G. Hormone crosstalk in plant disease and defense: More than just jasmonate–salicylate antagonism. Annu. Rev. Phytopathol. 2011, 49, 317–343. [Google Scholar] [CrossRef] [PubMed]
- Kazan, K.; Lyons, R. Intervention of phytohormone pathways by pathogen effectors. Plant Cell 2014, 26, 2285–2309. [Google Scholar] [CrossRef] [PubMed]
- Shigenaga, A.M.; Berens, M.L.; Tsuda, K.; Argueso, C.T. Towards engineering of hormonal crosstalk in plant immunity. Curr. Opin. Plant Biol. 2017, 38, 164–172. [Google Scholar] [CrossRef] [PubMed]
- Gilroy, E.; Breen, S. Interplay between phytohormone signalling pathways in plant defence—Other than salicylic acid and jasmonic acid. Essays Biochem. 2022, 66, 657–671. [Google Scholar] [CrossRef] [PubMed]
- Chanclud, E.; Morel, J.-B. Plant hormones: A fungal point of view. Mol. Plant Pathol. 2016, 17, 1289–1297. [Google Scholar] [CrossRef] [PubMed]
- Allen, M.F.; Moore, T.S., Jr.; Christensen, M. Phytohormone changes in Bouteloua gracilis infected by vesicular–arbuscular mycorrhizae: I. Cytokinin increases in the host plant. Can. J. Bot. 1980, 58, 371–374. [Google Scholar] [CrossRef]
- Norman, S.M.; Bennett, R.D.; Maier, V.P.; Poling, S.M. Cytokinins inhibit abscisic acid biosynthesis in Cercospora rosicola. Plant Sci. Lett. 1983, 28, 255–263. [Google Scholar] [CrossRef]
- Anand, G.; Gupta, R.; Marash, I.; Leibman-Markus, M.; Bar, M. Cytokinin production and sensing in fungi. Microbiol. Res. 2022, 262, 127103. [Google Scholar] [CrossRef] [PubMed]
- Romanov, G.A. How do cytokinins affect the cell? Russ. J. Plant Physiol. 2009, 56, 268–290. [Google Scholar] [CrossRef]
- Gupta, R.; Anand, G.; Pizarro, L.; Laor Bar-Yosef, D.; Kovetz, N.; Sela, N.; Yehuda, T.; Gazit, E.; Bar, M. Cytokinin inhibits fungal development and virulence by targeting the cytoskeleton and cellular trafficking. mBio 2021, 12, e0306820. [Google Scholar] [CrossRef]
- Anand, G.; Gupta, R.; Bar, M. Cytokinin regulates energy utilization in Botrytis cinerea. Cytokinin Botrytis Energy Status 2022, 10, e0306820. [Google Scholar] [CrossRef]
- Hartung, W. The evolution of abscisic acid (ABA) and ABA function in lower plants, fungi and lichen. Funct. Plant Biol. 2010, 37, 806–812. [Google Scholar] [CrossRef]
- Gill, A.; Patranabis, S. Phytohormones as potential anticancer agents. Int. J. Res. Appl. Sci. Biotechnol. 2021, 8, 37–43. [Google Scholar] [CrossRef]
- Spence, C.A.; Lakshmanan, V.; Donofrio, N.; Bais, H.P. Crucial roles of abscisic acid biogenesis in virulence of rice blast fungus Magnaporthe oryzae. Front. Plant Sci. 2015, 6, 1082. [Google Scholar] [CrossRef] [PubMed]
- Chen, D.; Shu, D.; Wei, Z.; Luo, D.; Yang, J.; Li, Z.; Tan, H. Combined transcriptome and proteome analysis of Bcfrp1 involved in regulating the biosynthesis of abscisic acid and growth in Botrytis cinerea TB-31. Front. Microbiol. 2023, 13, 1085000. [Google Scholar] [CrossRef] [PubMed]
- Herrera-Medina, M.J.; Steinkellner, S.; Vierheilig, H.; Ocampo Bote, J.A.; García Garrido, J.M. Abscisic acid determines arbuscule development and functionality in the tomato arbuscular mycorrhiza. New Phytol. 2007, 175, 554–564. [Google Scholar] [CrossRef] [PubMed]
- Ding, Z.; Zhang, Z.; Zhong, J.; Luo, D.; Zhou, J.; Yang, J.; Xiao, L.; Shu, D.; Tan, H. Comparative transcriptome analysis between an evolved abscisic acid-overproducing mutant Botrytis cinerea TBC-A and its ancestral strain Botrytis cinerea TBC-6. Sci. Rep. 2016, 6, 37487. [Google Scholar] [CrossRef] [PubMed]
- Chooi, Y.-H.; Muria-Gonzalez, M.J.; Solomon, P.S. A genome-wide survey of the secondary metabolite biosynthesis genes in the wheat pathogen Parastagonospora nodorum. Mycology 2014, 5, 192–206. [Google Scholar] [CrossRef] [PubMed]
- Downie, R.C.; Lin, M.; Corci, B.; Ficke, A.; Lillemo, M.; Oliver, R.P.; Phan, H.T.T.; Tan, K.-C.; Cockram, J. Septoria nodorum blotch of wheat: Disease management and resistance breeding in the face of shifting disease dynamics and a changing environment. Phytopathology 2021, 111, 906–920. [Google Scholar] [CrossRef] [PubMed]
- Haugrud, A.R.P.; Zhang, Z.; Friesen, T.L.; Faris, J.D. Genetics of resistance to septoria nodorum blotch in wheat. Theor. Appl. Genet. 2022, 135, 3685–3707. [Google Scholar] [CrossRef] [PubMed]
- Faris, J.D.; Zhang, Z.; Lu, H.; Lu, S.; Reddy, L.; Cloutier, S.; Fellers, J.P.; Meinhardt, S.W.; Rasmussen, J.B.; Xu, S.S.; et al. A unique wheat disease resistance-like gene governs effector-triggered susceptibility to necrotrophic pathogens. Proc. Natl. Acad. Sci. USA 2010, 107, 13544–13549. [Google Scholar] [CrossRef] [PubMed]
- Zhang, Z.; Friesen, T.L.; Xu, S.S.; Shi, G.J.; Liu, Z.H.; Rasmussen, J.B.; Faris, J. Two putatively homoeologous wheat genes mediate the recognition of SnTox3 to confer effector-triggered susceptibility to Stagonospora nodorum. Plant J. 2011, 65, 27–38. [Google Scholar] [CrossRef] [PubMed]
- Liu, Z.; Zhang, Z.; Faris, J.D.; Oliver, R.P.; Syme, R.; McDonald, M.C.; McDonald, B.A.; Solomon, P.S.; Lu, S.; Shelver, W.L.; et al. The cysteine rich necrotrophic effector SnTox1 produced by Stagonospora nodorum triggers susceptibility of wheat lines harboring Snn1. PLoS Pathog. 2012, 8, e1002467. [Google Scholar] [CrossRef] [PubMed]
- Richards, J.K.; Kariyawasam, G.K.; Seneviratne, S.; Wyatt, N.A.; Xu, S.S.; Liu, Z.; Faris, J.D.; Friesen, T.L. A triple threat: The Parastagonospora nodorum SnTox267 effector exploits three distinct host genetic factors to cause disease in wheat. New Phytol. 2022, 233, 427–442. [Google Scholar] [CrossRef] [PubMed]
- Kariyawasam, G.K.; Richards, J.K.; Wyatt, N.A.; Running, K.; Xu, S.S.; Liu, Z.; Bor-owicz, P.; Faris, J.D.; Friesen, T.L. The Parastagonospora nodorum necrotrophic effector SnTox5 targets the wheat gene Snn5 and facilitates entry into the leaf mesophyll. New Phytol. 2022, 233, 409–426. [Google Scholar] [CrossRef]
- Phan, H.T.T.; Rybak, K.; Furuki, E.; Breen, S.; Solomon, P.S.; Oliver, R.P.; Tan, K.C. Differential effector gene expression underpins epistasis in a plant fungal disease. Plant J. 2016, 87, 343–354. [Google Scholar] [CrossRef]
- John, E.; Jacques, S.; Phan, H.T.T.; Liu, L.; Pereira, D.; Croll, D.; Singh, K.B.; Oliver, R.P.; Tan, K.-C. Variability in an effector gene promoter of a necrotrophic fungal pathogen dictates epistasis and effector-triggered susceptibility in wheat. PLoS Pathog. 2022, 18, e1010149. [Google Scholar] [CrossRef] [PubMed]
- John, E.; Singh, K.B.; Oliver, R.P.; Tan, K.-C. Transcription factor control of virulence in phytopathogenic fungi. Mol. Plant Pathol. 2021, 22, 858–881. [Google Scholar] [CrossRef] [PubMed]
- IpCho, S.V.S.; Tan, K.-C.; Koh, G.; Gummer, J.; Oliver, R.P.; Trengove, R.D.; Solomon, P.S. The Transcription Factor StuA Regulates Central Carbon Metabolism, Mycotoxin Production, and Effector Gene Expression in the Wheat Pathogen Stagonospora nodorum. Eukaryot Cell 2010, 9, 1100–1108. [Google Scholar] [CrossRef] [PubMed]
- Rybak, K.; See, P.T.; Phan, H.T.T.; Syme, R.A.; Moffat, C.S.; Oliver, R.P.; Tan, K.-C. A functionally conserved Zn2Cys6 binuclear cluster transcription factor class regulates necrotrophic effector gene expression and host-specific virulence of two major Pleosporales fungal pathogens of wheat. Mol. Plant Pathol. 2017, 18, 420–434. [Google Scholar] [CrossRef] [PubMed]
- Lin, S.-Y.; Chooi, Y.-H.; Solomon, P.S. The global regulator of pathogenesis PnCon7 positively regulates Tox3 effector gene expression through direct interaction in the wheat pathogen Parastagonospora nodorum. Mol. Microbiol. 2018, 109, 78–90. [Google Scholar] [CrossRef] [PubMed]
- Veselova, S.V.; Nuzhnaya, T.V.; Burkhanova, G.F.; Rumyantsev, S.D.; Maksimov, I.V. Reactive oxygen species in host plant are required for an early defense response against attack of Stagonospora nodorum Berk. necrotrophic effectors SnTox. Plants 2021, 10, 1586. [Google Scholar] [CrossRef] [PubMed]
- Nuzhnaya, T.; Veselova, S.; Burkhanova, G.; Rumyantsev, S.; Shoeva, O.; Shein, M.; Maksimov, I. Novel sources of resistance to Stagonospora nodorum and role of effec-tor-susceptibility gene interactions in wheat of russian breeding. Int. J. Plant Biol. 2023, 14, 377–396. [Google Scholar] [CrossRef]
- Veselov, S.Y.; Timergalina, L.N.; Akhiyarova, G.R.; Kudoyarova, G.R.; Korobova, A.V.; Ivanov, I.; Arkhipova, T.N.; Prinsen, E. Study of cytokinin transport from shoots to roots of wheat plants is informed by a novel method of differential localization of free cytokinin bases or their ribosylated forms by means of their specific fixation. Proto-Plasma 2018, 255, 1581–1594. [Google Scholar] [CrossRef] [PubMed]
- Kudoyarova, G.R.; Veselov, D.S.; Sharipova, G.V.; Akhiyarova, R.G.; Dodd, I.C.; Veselov, S.Y. Water relations and growth of original barley plants and its ABA-deficient mutants at increased air temperature. Russ. J. Plant Physiol. 2014, 61, 188–193. [Google Scholar] [CrossRef]
- Kudoyarova, G.R.; Korobova, A.V.; Akhiyarova, G.R.; Arkhipova, T.N.; Zaytsev, D.Y.; Prinsen, E.; Egutkin, N.L.; Medvedev, S.S.; Veselov, S.Y. Accumulation of cytokinins in roots and their export to the shoots of durum wheat plants treated with the protonophore carbonyl cyanide m-chlorophenylhydrazone (CCCP). J. Exp. Bot. 2014, 65, 2287–2294. [Google Scholar] [CrossRef] [PubMed]
- Netrusov, A.I.; Egorova, M.A.; Zakharchuk, L.M.; Kolotilova, N.N. Workshop on Microbiology: Textbook for Students of Higher Educational Institutions; Netrusov, A.I., Ed.; Publishing Center “Academy”: Moscow, Russia, 2005; p. 608. [Google Scholar]
- Veselova, S.V.; Sorokan, A.V.; Burkhanova, G.F.; Rumyantsev, S.D.; Cherepanova, E.A.; Alekseev, V.Y.; Sarvarova, E.R.; Kasimova, A.R.; Maksimov, I.V. By Modulating the Hormonal Balance and Ribonuclease Activity of Tomato Plants Bacillus subtilis Induces Defense Response against Potato Virus X and Potato Virus Y. Biomolecules 2022, 12, 288. [Google Scholar] [CrossRef] [PubMed]
- Kind, S.; Hinsch, J.; Vrabka, J.; Hradilová, M.; Majeská-Čudejková, M.; Tudzynski, P.; Galuszka, P. Manipulation of cytokinin level in the ergot fungus Claviceps purpurea emphasizes its contribution to virulence. Curr. Genet. 2018, 64, 1303–1319. [Google Scholar] [CrossRef] [PubMed]
- Bruce, S.A.; Saville, B.J.; Neil Emery, R.J. Ustilago maydis produces cytokinins and abscisic acid for potential regulation of tumor formation in maize. J. Plant Growth Regul. 2011, 30, 51–63. [Google Scholar] [CrossRef]
- Lievens, L.; Pollier, J.; Goossens, A.; Beyaert, R.; Staal, J. Abscisic acid as pathogen effector and immune regulator. Front. Plant Sci. 2017, 8, 587. [Google Scholar] [CrossRef] [PubMed]
- Lee, B.O. Effect of kinetin on the fertility of some strains of Neurospora crassa. Nature 1961, 192, 288. [Google Scholar] [CrossRef]
- Park, H.-S.; Yu, J.-H. Genetic control of asexual sporulation in filamentous fungi. Curr. Opin. Microbiol. 2012, 15, 669–677. [Google Scholar] [CrossRef] [PubMed]
- Lowe, R.G.T.; Lord, M.; Rybak, K.; Trengove, R.D.; Oliver, R.P.; Solomon, P.S. Trehalose biosynthesis is involved in sporulation of Stagonospora nodorum. Fungal Genet. Biol. 2009, 46, 381–389. [Google Scholar] [CrossRef] [PubMed]
- Solomon, P.S.; Waters, O.D.C.; Jorgens, C.I.; Lowe, R.G.T.; Rechberger, J.; Trengove, R.D.; Oliver, R.P. Mannitol is required for asexual sporulation in the wheat pathogen Stagonospora nodorum (glume blotch). Biochem. J. 2006, 399, 231–239. [Google Scholar] [CrossRef] [PubMed]
- Wang, Z.L.; Lu, J.; Feng, M.G. Primary roles of two dehydrogenases in the mannitol metabolism and multi-stress tolerance of entomopathogenic fungus Beauveria bassiana. Environ. Microbiol. 2012, 14, 2139–2150. [Google Scholar] [CrossRef]
- Faris, J.D.; Zhang, Z.; Rasmussen, J.B.; Friesen, T.L. Variable expression of the Stagonospora nodorum effector SnToxA among isolates is correlated with levels of disease in wheat. MPMI 2011, 24, 1419–1426. [Google Scholar] [CrossRef] [PubMed]
- Haugrud, A.R.P.; Zhang, Z.; Richards, J.K.; Friesen, T.L.; Faris, J.D. Genetics of variable disease expression conferred by inverse gene-for-gene interactions in the wheat-Parastagonospora nodorum pathosystem. Plant Physiol. 2019, 180, 420–434. [Google Scholar] [CrossRef] [PubMed]
- Friesen, T.L.; Stukenbrock, E.H.; Liu, Z.H.; Meinhardt, S.; Ling, H.; Faris, J.D.; Rasmussen, J.B.; Solomon, P.S.; McDonald, B.A.; Oliver, R.P. Emergence of a new disease as a result of interspecific virulence gene transfer. Nat. Genet. 2006, 38, 953–956. [Google Scholar] [CrossRef] [PubMed]
- Liu, Z.H.; Friesen, T.L.; Rasmussen, J.B.; Ali, S.; Meinhardt, S.W.; Faris, J.D. Quantitative trait loci analysis and mapping of seedling resistance to Stagonospora nodorum leaf blotch in wheat. Phytopathology 2004, 94, 1061–1067. [Google Scholar] [CrossRef] [PubMed]
- Anderson, J.P.; Badruzsaufari, E.; Schenk, P.M.; Manners, J.M.; Desmond, O.J.; Ehlert, C.; Maclean, D.J.; Ebert, P.R.; Kazanet, K. Antagonistic interaction between abscisic acid and jasmonate-ethylene signaling pathways modulates defense gene expression and disease resistance in Arabidopsis. Plant Cell 2004, 16, 3460–3479. [Google Scholar] [CrossRef] [PubMed]
- Fan, J.; Hill, L.; Crooks, C.; Doerner, P.; Lamb, C. Abscisic acid has a key role in modulating diverse plant-pathogen interactions. Plant Physiol. 2009, 150, 1750–1761. [Google Scholar] [CrossRef] [PubMed]
- Jiang, C.J.; Shimono, M.; Sugano, S.; Kojima, M.; Yazawa, K.; Yoshida, R.; Inoue, H.; Nagao, H.; Sakakibara, H.; Takatsuji, H. Abscisic acid interacts antagonistically with salicylic acid signaling pathway in rice-Magnaporthe grisea interaction. Mol. Plant Microbe Interact. 2010, 23, 791–798. [Google Scholar] [CrossRef] [PubMed]
- Morrison, E.N.; Neil Emery, R.J.; Savilleet, B.J. Phytohormone Involvement in the Ustilago maydis–Zea mays Pathosystem: Relationships between Abscisic Acid and Cytokinin Levels and Strain Virulence in Infected Cob Tissue. PLoS ONE 2015, 10, e0130945. [Google Scholar] [CrossRef] [PubMed]
- Chanclud, E.; Kisiala, A.; Emery, N.R.J.; Chalvon, V.; Ducasse, A.; Romiti-Michel, C.; Gravot, A.; Kroj, T.; Morelet, J. Cytokinin production by the rice blast fungus is a pivotal requirement for full virulence. PLoS Pathog. 2016, 12, e1005457. [Google Scholar] [CrossRef] [PubMed]
- Babosha, A.V. Regulation of resistance and susceptibility in wheat powdery mildew pathosystem with exogenous cytokinins. J. Plant Physiol. 2009, 166, 1892–1903. [Google Scholar] [CrossRef] [PubMed]

| Parameter | Isolate S. nodorum | ABA | IAA | Cytokinins * |
|---|---|---|---|---|
| Hormone Level, ng/g Fresh Weight in Fungal Mycelium | SnB | 36.9 ± 2.8 a | 79.8 ± 1.9 b | 0.7 ± 0.01 d |
| Sn9MN-3A | 21.9 ± 1.6 b | 76.2 ± 3.9 b | 12.2 ± 1.2 b | |
| Sn4VD | 13.9 ± 0.4 c | 143.4 ± 15.0 a | 121.9 ± 9.3 a | |
| Hormone Level, ng/mL of Culture Medium | SnB | 15.7 ± 1.0 c | 20.5 ± 1.2 d | 0.05 ± 0.001 d |
| Sn9MN-3A | 12.1 ± 0.8 c | 20.6 ± 3.5 d | 3.0 ± 0.6 c | |
| Sn4VD | 17.7 ± 1.7 bc | 42.9 ± 4.1 c | 10.7 ± 0.9 b | |
| CM ** | 0.83 ± 0.01 d | 0.08 ± 0.001 e | 0.1 ± 0.005 d |
Disclaimer/Publisher’s Note: The statements, opinions and data contained in all publications are solely those of the individual author(s) and contributor(s) and not of MDPI and/or the editor(s). MDPI and/or the editor(s) disclaim responsibility for any injury to people or property resulting from any ideas, methods, instructions or products referred to in the content. |
© 2024 by the authors. Licensee MDPI, Basel, Switzerland. This article is an open access article distributed under the terms and conditions of the Creative Commons Attribution (CC BY) license (https://creativecommons.org/licenses/by/4.0/).
Share and Cite
Nuzhnaya, T.V.; Sorokan, A.V.; Burkhanova, G.F.; Maksimov, I.V.; Veselova, S.V. The Role of Cytokinins and Abscisic Acid in the Growth, Development and Virulence of the Pathogenic Fungus Stagonospora nodorum (Berk.). Biomolecules 2024, 14, 517. https://doi.org/10.3390/biom14050517
Nuzhnaya TV, Sorokan AV, Burkhanova GF, Maksimov IV, Veselova SV. The Role of Cytokinins and Abscisic Acid in the Growth, Development and Virulence of the Pathogenic Fungus Stagonospora nodorum (Berk.). Biomolecules. 2024; 14(5):517. https://doi.org/10.3390/biom14050517
Chicago/Turabian StyleNuzhnaya, Tatyana V., Antonina V. Sorokan, Guzel F. Burkhanova, Igor V. Maksimov, and Svetlana V. Veselova. 2024. "The Role of Cytokinins and Abscisic Acid in the Growth, Development and Virulence of the Pathogenic Fungus Stagonospora nodorum (Berk.)" Biomolecules 14, no. 5: 517. https://doi.org/10.3390/biom14050517
APA StyleNuzhnaya, T. V., Sorokan, A. V., Burkhanova, G. F., Maksimov, I. V., & Veselova, S. V. (2024). The Role of Cytokinins and Abscisic Acid in the Growth, Development and Virulence of the Pathogenic Fungus Stagonospora nodorum (Berk.). Biomolecules, 14(5), 517. https://doi.org/10.3390/biom14050517

